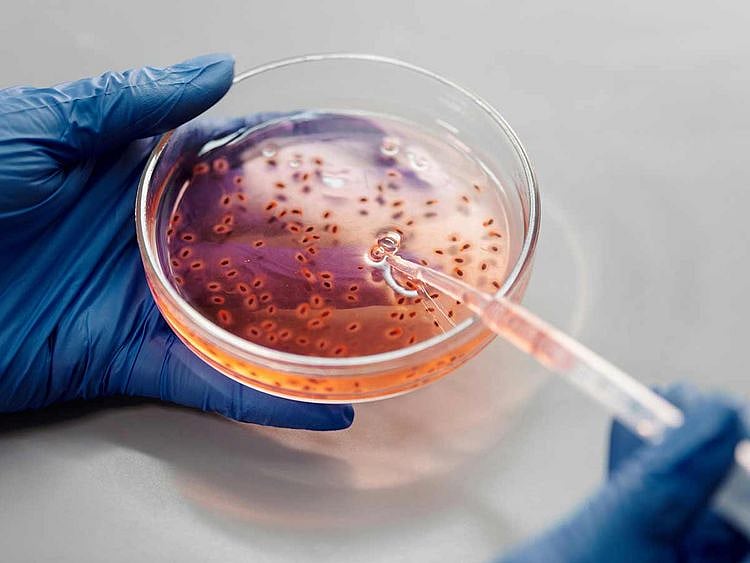
Brazil records world's first Oropouche virus deaths

2 women from the state of Bahia died of the illness spread by infected flies and mosquitos
Sao Paulo: Brazil has recorded the world's first Oropouche virus deaths, the country's health ministry said Thursday, after two women died of the illness spread by infected flies and mosquitos.
The women from the state of Bahia in northeast Brazil were "under 30 years old, with no comorbidities, but who had signs and symptoms similar to a severe case of dengue," the ministry said in a statement.
The US Centers for Disease Control and Prevention website states there are currently known outbreaks of Oropouche in parts of Bolivia, Brazil, Colombia, Cuba and Peru.
The Brazil health ministry said there have been 7,236 cases of Oropouche infection recorded in 2024, with the majority being reported out of the states of Amazonas and Rondonia.
According to the CDC, symptoms of Oropouche viral infection usually begin four to eight days after being bitten.
Symptoms typically last for three to six days, the health agency said, with similar symptoms to dengue, such as fever, muscle aches, stiff joints, headache, vomiting, nausea, chills or sensitivity to light.
Severe cases can result in life-threatening complications such as meningitis.
Oropouche was first isolated in Brazil in 1960, according to the health ministry.
Most cases have been reported in the Amazon region of Brazil but outbreaks and isolated cases have been reported elsewhere in Latin America.
Sign up for the Daily Briefing
Get the latest news and updates straight to your inbox
Network Links
GN StoreDownload our app
© Al Nisr Publishing LLC 2026. All rights reserved.